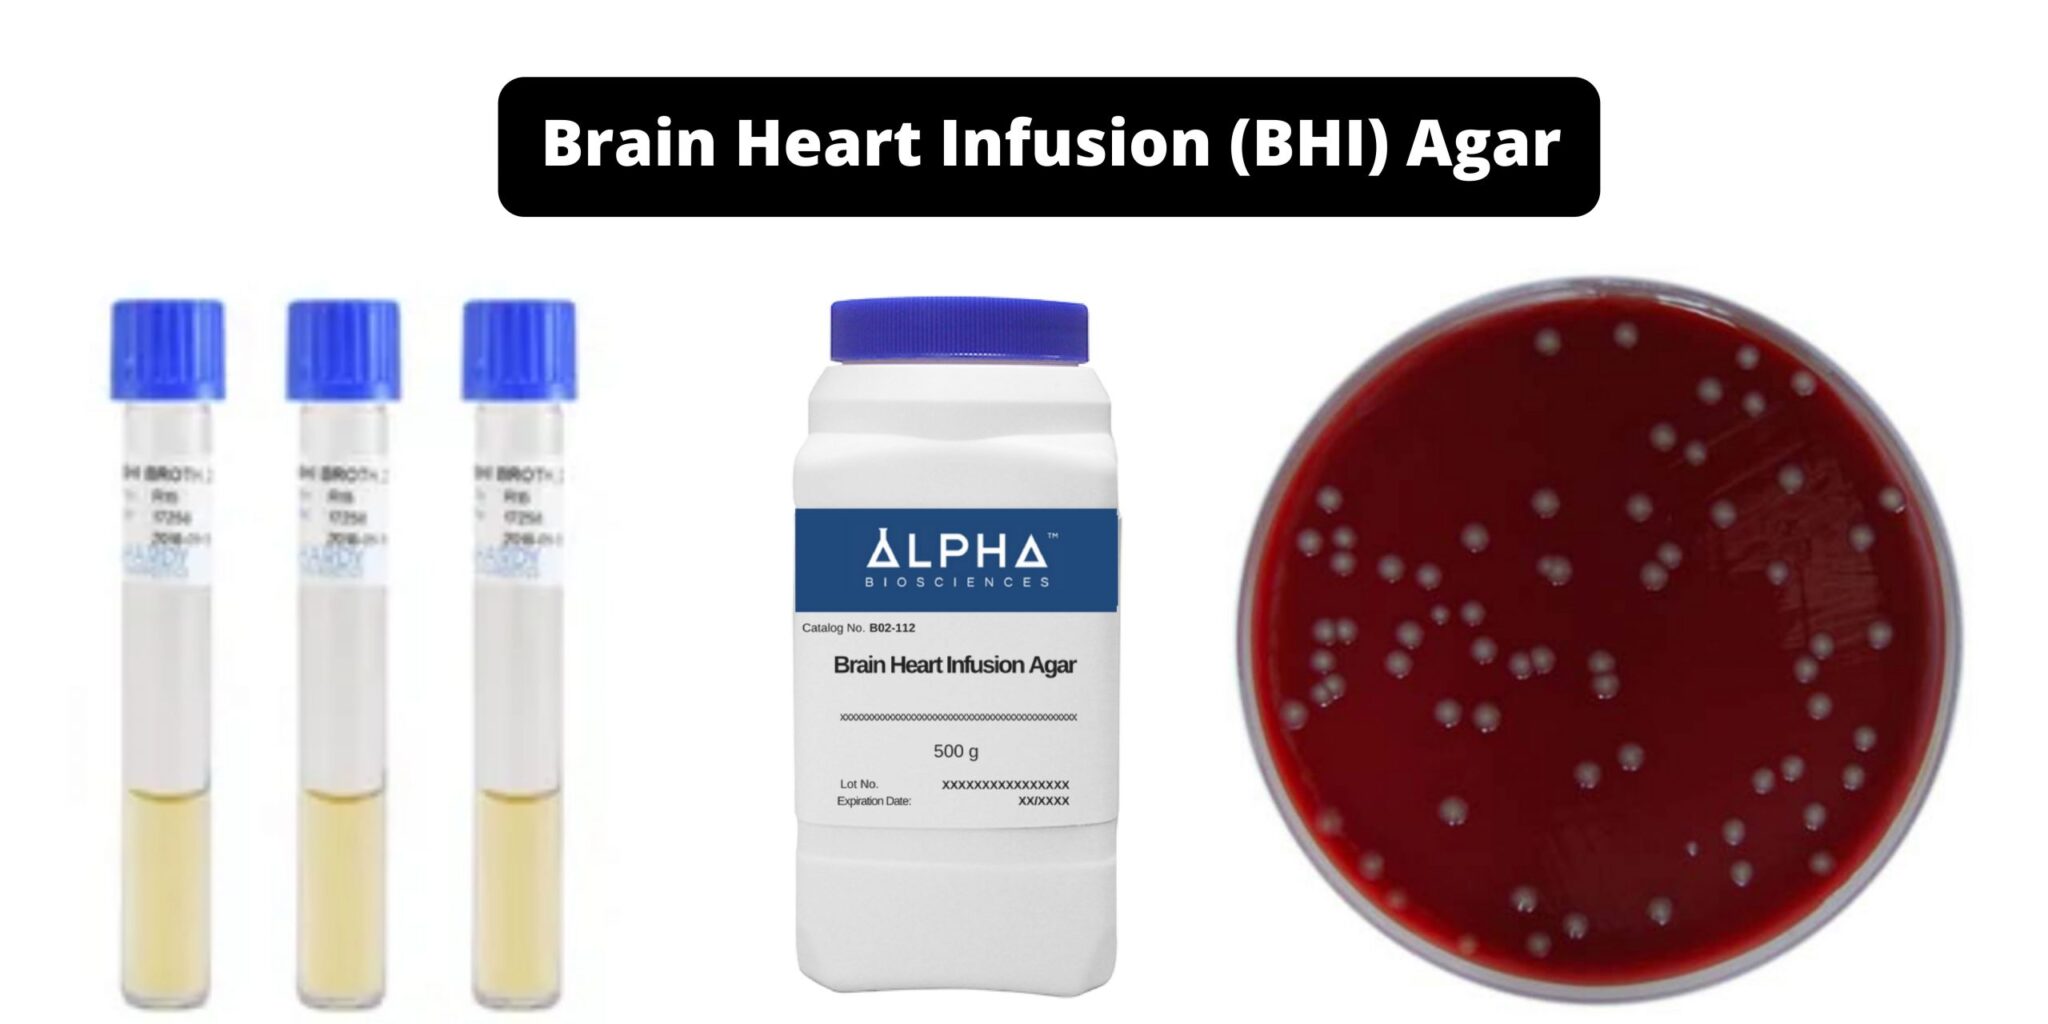

Define Composition In Biology Learn how to remove restrictions on adult content access on Virgin Media even when child safety settings are reportedly off
Aug 14 2023 nbsp 0183 32 Pornhub 12 May 5 2020 nbsp 0183 32 pornhub OFF
Define Composition In Biology

Define Composition In Biology
https://i.pinimg.com/originals/f9/4c/b3/f94cb30db1edb33ffcf656fd86ba0c55.png

20 Composition Techniques That Will Improve Your Photos Photography
https://i.pinimg.com/originals/06/28/9a/06289a5e8752454a3a481eb90d985c8c.jpg

Blood Definition Composition And Functions
https://easybiologynotes.com/wp-content/uploads/2024/10/Composition-of-Blood.jpg
Apr 12 2024 nbsp 0183 32 Pornhub May 23 2023 nbsp 0183 32 Pornhub pornhub com XVIDEOS xvideos com
Jan 26 2025 nbsp 0183 32 HazeyHaley YouTube How can I access adult sites I have a new router Every setting is correct the access is allowed but nothing is connectingsomeone please help amp nbsp 5531529
More picture related to Define Composition In Biology

Genome Definition And Examples Biology Online Dictionary
https://www.biologyonline.com/wp-content/uploads/2019/10/genome-definition-and-example.jpg

MOTYFF Modelling Typical Families In Flanders Kristel Bogaerts Natascha
https://images.slideplayer.com/32/10010766/slides/slide_9.jpg

Baird Parker Agar
https://notesforbiology.com/wp-content/uploads/2024/05/Baird-Parker-Agar-Composition-Principle-Preparation-Results-Uses.png
Apr 17 2023 nbsp 0183 32 Pornhub 12 Apr 9 2024 nbsp 0183 32
[desc-10] [desc-11]

Television Composition Mastering The Art Of Visual Storytelling Amra
https://s.studiobinder.com/wp-content/uploads/2020/12/Rules-of-Shot-Composition-in-Film-Film-Composition-Explained-scaled.jpg
CLED Agar Composition Principle Preparation Results Uses
https://biologynotesonline.com/wp-content/uploads/2022/01/Brain-Heart-Infusion-BHI-Agar-scaled-1-2048x1024.jpg
Define Composition In Biology - May 23 2023 nbsp 0183 32 Pornhub pornhub com XVIDEOS xvideos com